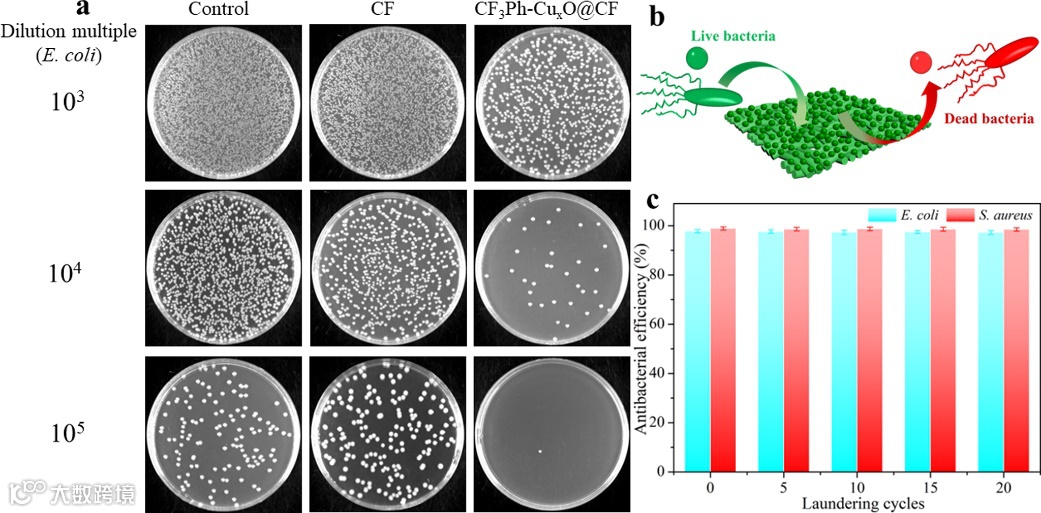

超疏水表面由于其在处理界面问题上的独特优势,而引起了学术界和工业界的广泛关注和研究兴趣,例如:防粘、自清洁、抗菌、抗结冰、防腐蚀、微反应器等。古有诗词“出淤泥而不染,濯清涟而不妖”,这其中描述的就是“荷叶效应”。荷叶表面因其具有特殊微/纳米多级乳突结构和低表面能蜡质的协同作用而表现出优异的低粘附力超疏水性能。超疏水性能是由低表面能化学物质的疏水性协同多级糙化结构的结果,因此以这两个因素为出发点是制备超疏水表面的关键。基于纺织品的超疏水表面尤其受到关注,而赋予纺织品多功能化也越来越重要,以满足其在各种工作环境下的多重应用需求。此外,较差的机械稳定性也一直阻碍了其在现实生活中的应用进展。同时,通常制备超疏水表面具有诸多不足之处,如:设备要求苛刻、操作复杂、成本高等,特别是对于纺织品而言。因此,通过简单易操作、成本低廉、环保的工艺制备具有粗糙形貌结构可控、优异牢度的多功能超疏水织物,依旧是一个很大的挑战。
鉴于此,苏州大学李战雄教授课题组和新加坡国立大学Tan Swee Ching教授课题组基于重氮自由基聚合的方法,以含不同官能团的芳香聚合单体对棉织物进行接枝改性,巧妙的通过VC二次还原在纤维表面成功构筑了具有不同形貌的多级糙化结构,利用其金属的独特性能进而实现了具有不同优异特性的多功能超疏水纺织品的成功制备,例如:展现出优良的自清洁、自愈、抗紫外线、抗结冰和抗菌等功能。

图1. 多功能超疏水织物图文摘要示意图

图2. 不同芳香重氮自由基单体调控金属有机复合材料纤维表面原位构筑多级糙化结构纺织品的反应机理图及电镜图。

图3. (a) CF的ATR-FTIR,(e) XPS和(i)XRD光谱图,NO2Ph-CuxO@CF, CF3Ph-CuxO@CF和DCF3Ph-CuxO@CF。NO2Ph-CuxO@CF (b-d)、CF3Ph-CuxO@CF (f-h)和DCF3Ph-CuxO@CF (j-l)的XPS高分辨率C 1s、N 1s和Cu 2p光谱图。

图4. 不同芳香单体调控制备样品的润湿性能对比。

图5. (a) CF3Ph-CuxO@CF表面O2等离子体溅射和高温自修复机理示意图。(b)在O2等离子体溅射和自修复过程中制备的织物表面在超疏水(左)和超亲水(右)状态之间的可逆转变。(c) 15次循环O2等离子体和热处理后织物WCA的变化。CF3Ph-CuxO@CF织物的洗涤(d)和磨擦(e)耐久性能。

图6. CF3Ph-CuxO@CF自清洁(a)和油水分离(b:石油醚,c:四氯化碳)过程图。(d)油水分离可回收分离循环性能和(e)不同油水混合物的分离效率。

图7. (a) CF3Ph-CuxO@CF的抗紫外线和防结冰性能示意图。(b) CF和CF3Ph-CuxO@CF的UV透过率曲线和(c) UPF、UVB和UVA值。(d)红外相机记录下的水滴表面温度随冷却时间的曲线图。(e-g)水滴冻结前、冻结中、冻结后的红外图像及其对应的温度和时间。
图8. (a)孵育18小时后,不同稀释倍数下琼脂平板上形成的大肠杆菌菌落照片。(b) CF3Ph-CuxO@CF抗菌性能示意图。(c) CF3Ph-CuxO@CF对大肠杆菌和金黄色葡萄球菌抗菌性能的耐皂洗牢度。
小结:作者采用重氮自由基聚合法在室温条件下协同CuxO糙化改性棉织物,制备得到了具有粗糙结构形貌可控且耐30次皂洗和1500次机械摩擦牢度的多功超疏水织物,同时展现出优异的自愈性、自清洁、油水分离、抗紫外线、防结冰、抗菌等性能。该方法操作简单、反应条件温和、成本低廉,为制备多功能、高附加值纺织品,拓展纺织品实际应用前景提出了一种实际可行的方案,并为替代长碳链全氟烷基聚合物接枝改性纤维原位“糙化”精确调控构筑纤维表面涂层结构,最大限度发挥其拒液性能指明了方向。
相关成果以题为A facile strategy to prepare robust self-healable superhydrophobic fabrics with self-cleaning, anti-icing, UV resistance, and antibacterial properties的论文发表在Chemical Engineering Journal上。其中论文的第一作者为苏州大学纺织与服装工程学院博士生李武龙,通讯作者为苏州大学李战雄教授,新加坡国立大学Tan Swee Ching教授。该工作得到了国家自然科学基金(No. 51673137),江苏省研究生科研与实践创新计划项目(No. KYCX20-2665),中国国家留学基金委 (CSC, 202106920042)和江苏省高等学校重点学术项目建设的支持。
原文链接:
A facile strategy to prepare robust self-healable superhydrophobic fabrics with self-cleaning, anti-icing, UV resistance, and antibacterial properties
Wulong Li, Kexin Liu, Yaoxin Zhang, Shuai Guo, Zhanxiong Li*, Swee Ching Tan*
https://doi.org/10.1016/j.cej.2022.137195
https://www.sciencedirect.com/science/article/pii/S1385894722026845
相关进展
苏州大学李战雄课题组《Surf. Coat. Technol.》:基于重氮化学一步法制备多级糙化结构仿生多功能超疏水织物
浙大成少安和新加坡国立大学Tan Swee Ching等 Nano energy:生物复合水凝胶为吸收体的多热源驱动的界面蒸发

高分子科技原创文章。欢迎个人转发和分享,刊物或媒体如需转载,请联系邮箱:info@polymer.cn


诚邀投稿
欢迎专家学者提供稿件(论文、项目介绍、新技术、学术交流、单位新闻、参会信息、招聘招生等)至info@polymer.cn,并请注明详细联系信息。高分子科技®会及时推送,并同时发布在中国聚合物网上。
欢迎加入微信群 为满足高分子产学研各界同仁的要求,陆续开通了包括高分子专家学者群在内的几十个专项交流群,也包括高分子产业技术、企业家、博士、研究生、媒体期刊会展协会等群,全覆盖高分子产业或领域。目前汇聚了国内外高校科研院所及企业研发中心的上万名顶尖的专家学者、技术人员及企业家。
申请入群,请先加审核微信号PolymerChina (或长按下方二维码),并请一定注明:高分子+姓名+单位+职称(或学位)+领域(或行业),否则不予受理,资格经过审核后入相关专业群。

点
这里“阅读原文”,查看更多



